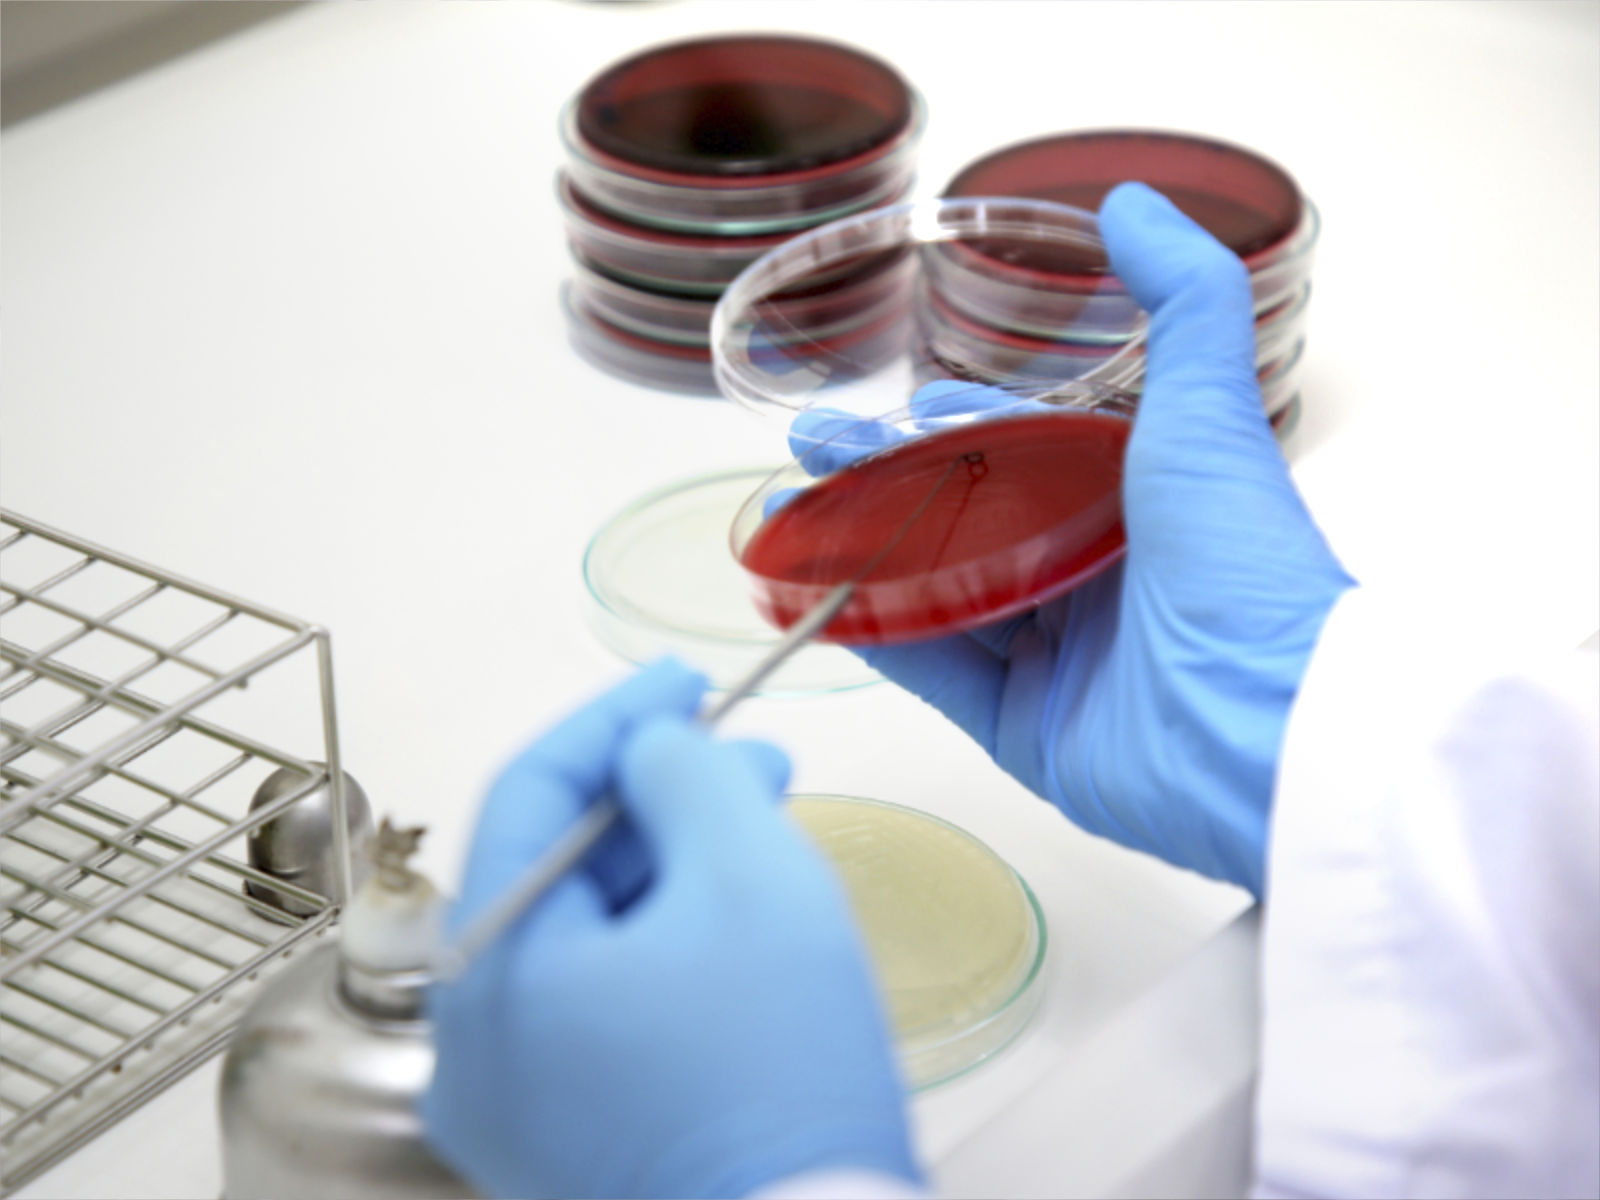

ครอบคลุมการวิจัย พัฒนา ควบคุมคุณภาพ และการผลิตในระดับอุตสาหกรรม
ด้วยเทคโนโลยี Spray Dry และ Encapsulation ภายใต้มาตรฐานสากล

จุดเริ่มต้นของการพัฒนาสูตรวัตถุดิบ
ในทุกการพัฒนาสูตรของ MTF จุดเริ่มต้นสำคัญอยู่ในห้องวิจัยและพัฒนาที่ออกแบบมาเพื่อการสร้างสรรค์อย่างแท้จริง ภายในประกอบด้วยเทคโนโลยีควบคุมสมัยใหม่และอุปกรณ์ที่ช่วยให้ทีม R&D ทำงานได้อย่างแม่นยำ เรามุ่งพัฒนาผงวัตถุดิบที่คงรูป รส กลิ่น สี และคุณค่าทางโภชนาการไว้อย่างครบถ้วน เพื่อให้สามารถนำไปประยุกต์ใช้ได้อย่างเหมาะสมในทุกกลุ่มอุตสาหกรรมอาหาร ผลลัพธ์คือส่วนผสมที่พร้อมรองรับการผลิตจริง และช่วยให้ลูกค้าพัฒนาผลิตภัณฑ์ได้อย่างมั่นใจยิ่งขึ้น

ควบคุมคุณภาพในทุกขั้นตอนการผลิต

กระบวนการผลิตที่แม่นยำและสม่ำเสมอ
กระบวนการผลิตของ MTF ถูกออกแบบให้เป็นระบบที่แม่นยำและควบคุมได้ทุกขั้นตอน ตั้งแต่การคัดเลือกวัตถุดิบ การเตรียมส่วนผสม การแปรรูปด้วยเทคโนโลยี Spray Dry และ Encapsulation ไปจนถึงการบรรจุและตรวจสอบขั้นสุดท้าย โดยทุกฝ่ายต่างทำงานร่วมกันอย่างบูรณาการและใกล้ชิดเพื่อให้ทุกการผลิตมีความสม่ำเสมอ ปลอดภัย และพร้อมใช้งานในสายการผลิตของลูกค้า ดังนั้นกระบวนการทั้งหมดจึงไม่เพียงตอบโจทย์คุณภาพ แต่ยังรองรับการผลิตในระดับอุตสาหกรรมได้อย่างมีประสิทธิภาพ

จัดเก็บและควบคุมคุณภาพอย่างเป็นระบบ